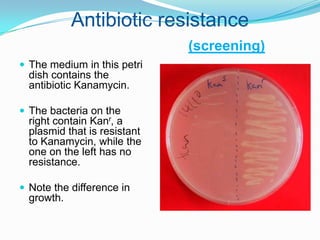
Antibiotic resistance(screening)The medium in this petri dish contains the antibiotic Kanamycin.The bacteria on the right contain Kanr, a plasmid that is resistant to Kanamycin, while the one on the left has no resistance.Note the difference in growth.

Gene cloning involves making many identical copies of a gene. It differs from cloning an entire organism. Gene cloning is done to isolate and study particular genes, identify control sequences and mutations, and engineer organisms for specific purposes like insulin production. It is accomplished by extracting DNA from an organism, cutting it into pieces with restriction enzymes, and inserting the gene of interest into bacterial plasmids which are then taken up by bacteria. This allows the gene to be amplified as the bacteria containing the recombinant plasmid multiply. PCR is another method that amplifies DNA fragments in vitro using heat-stable DNA polymerase and repeated heating and cooling cycles.